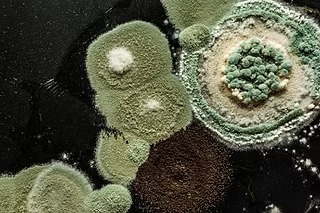
image

Built Environments Enhances Saskatoon Safety with Air Quality Testing
Built Environments offers essential asbestos testing services and specialized indoor air quality test mold detection in Saskatoon. Their professional team ensures accurate data collection and analysis, helping clients identify and manage environmental risks for healthier, safer properties.
To learn more, visit: https://www.builtenvironments.ca/services